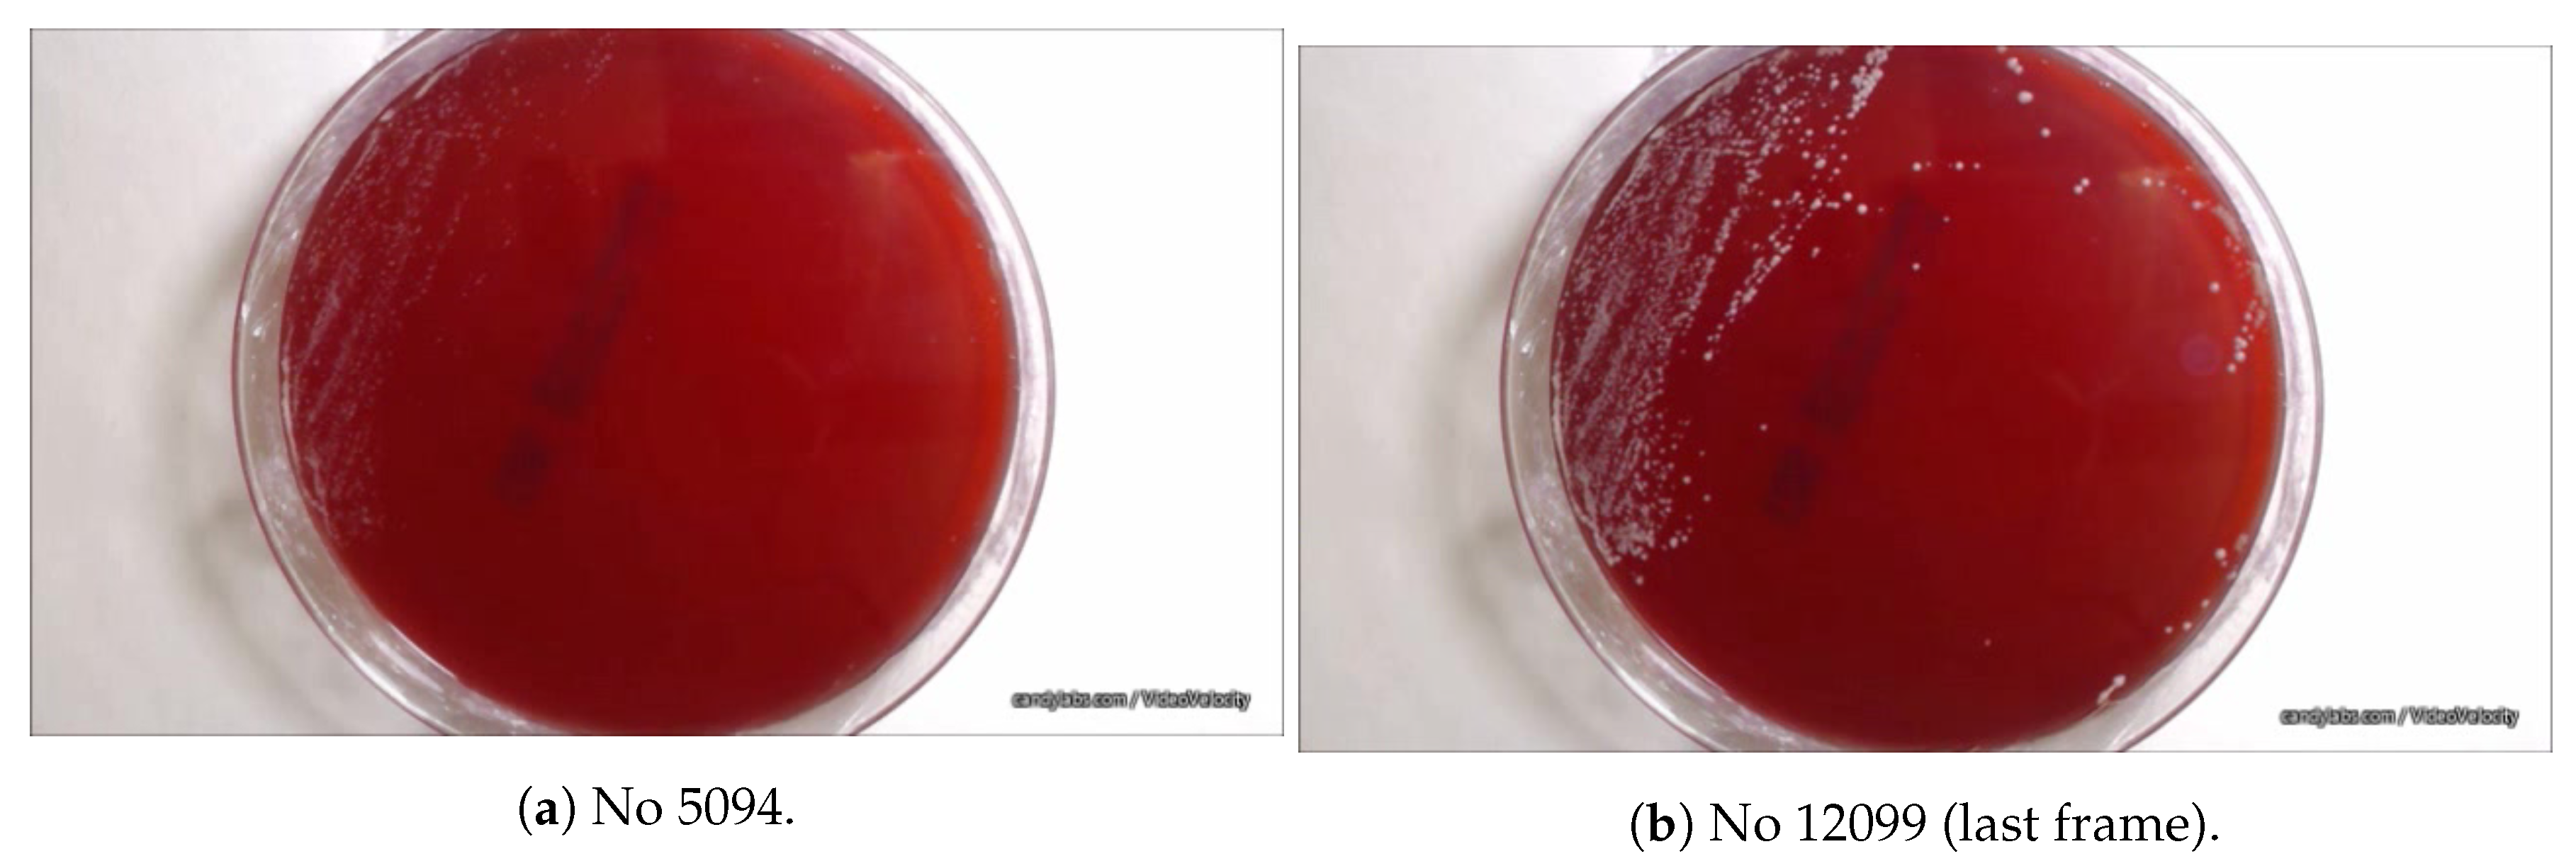
Sensors 20 02545 g002
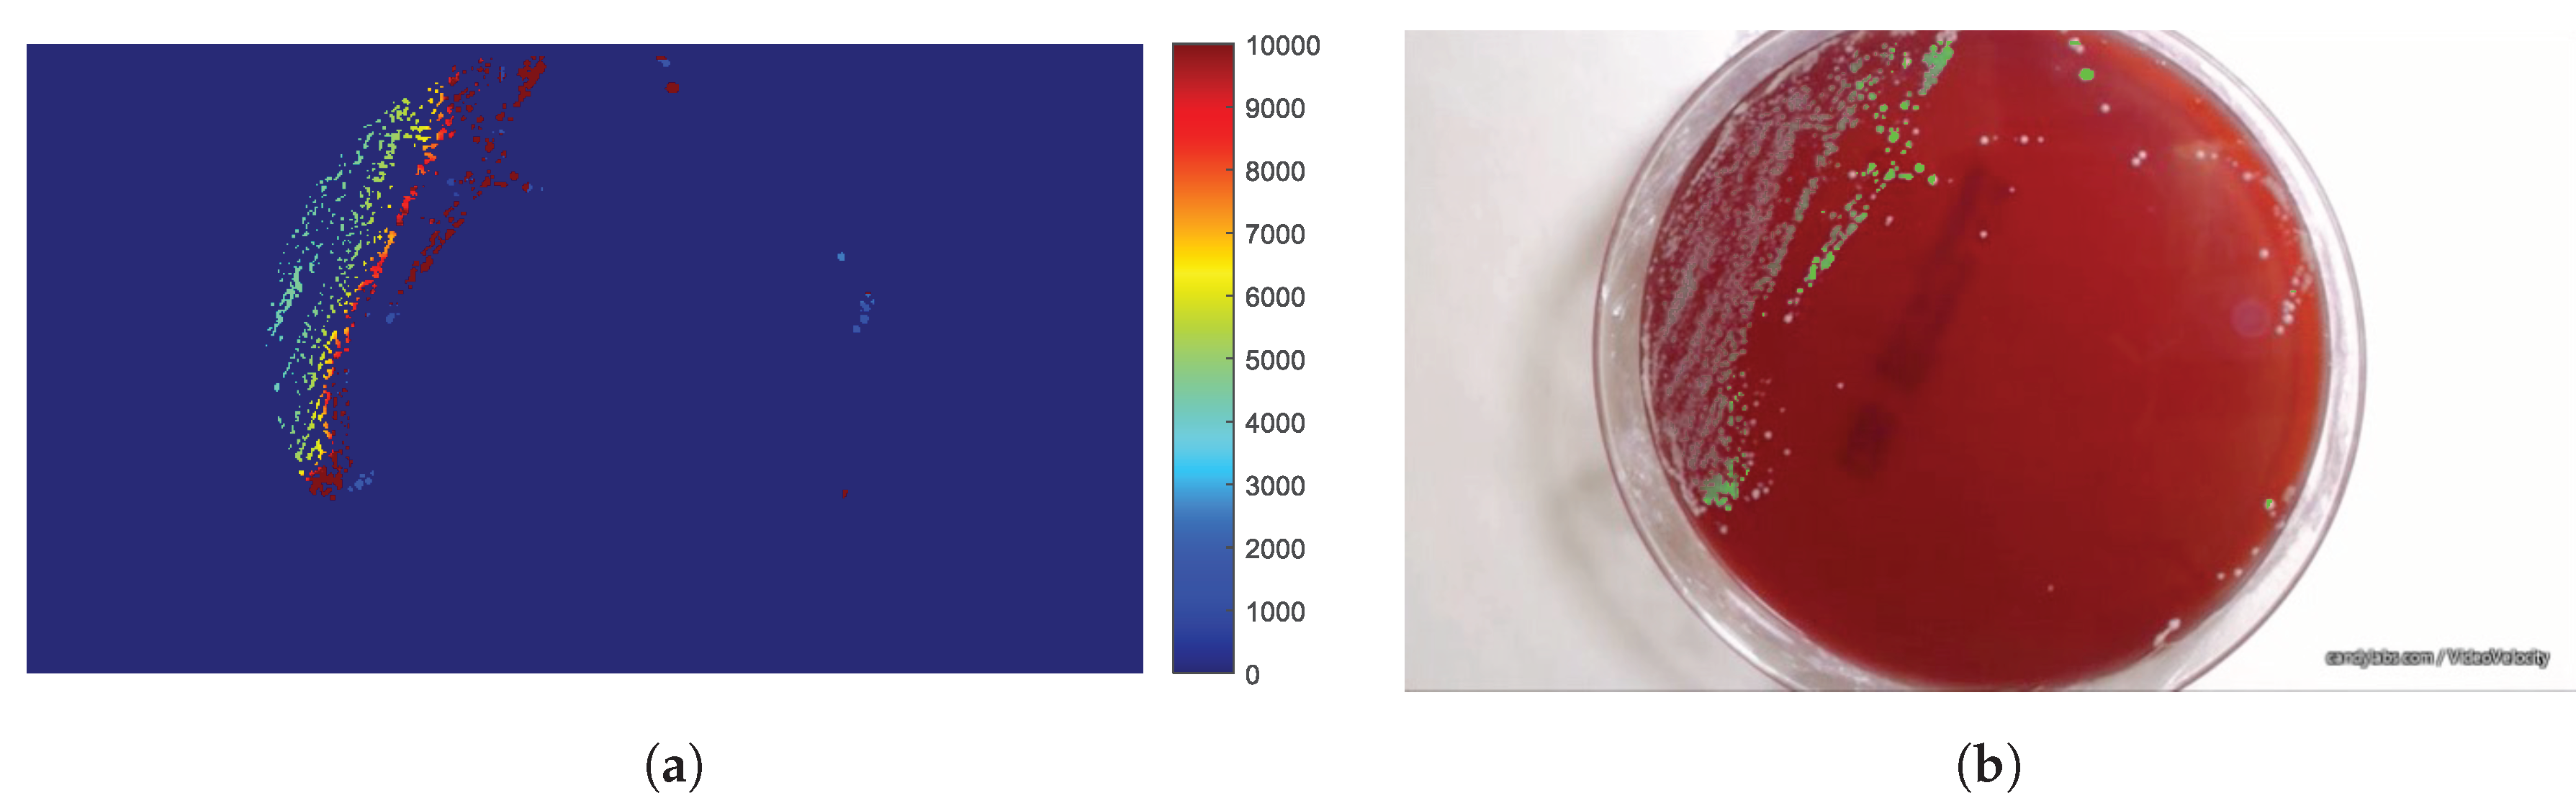
Sensors 20 02545 g013
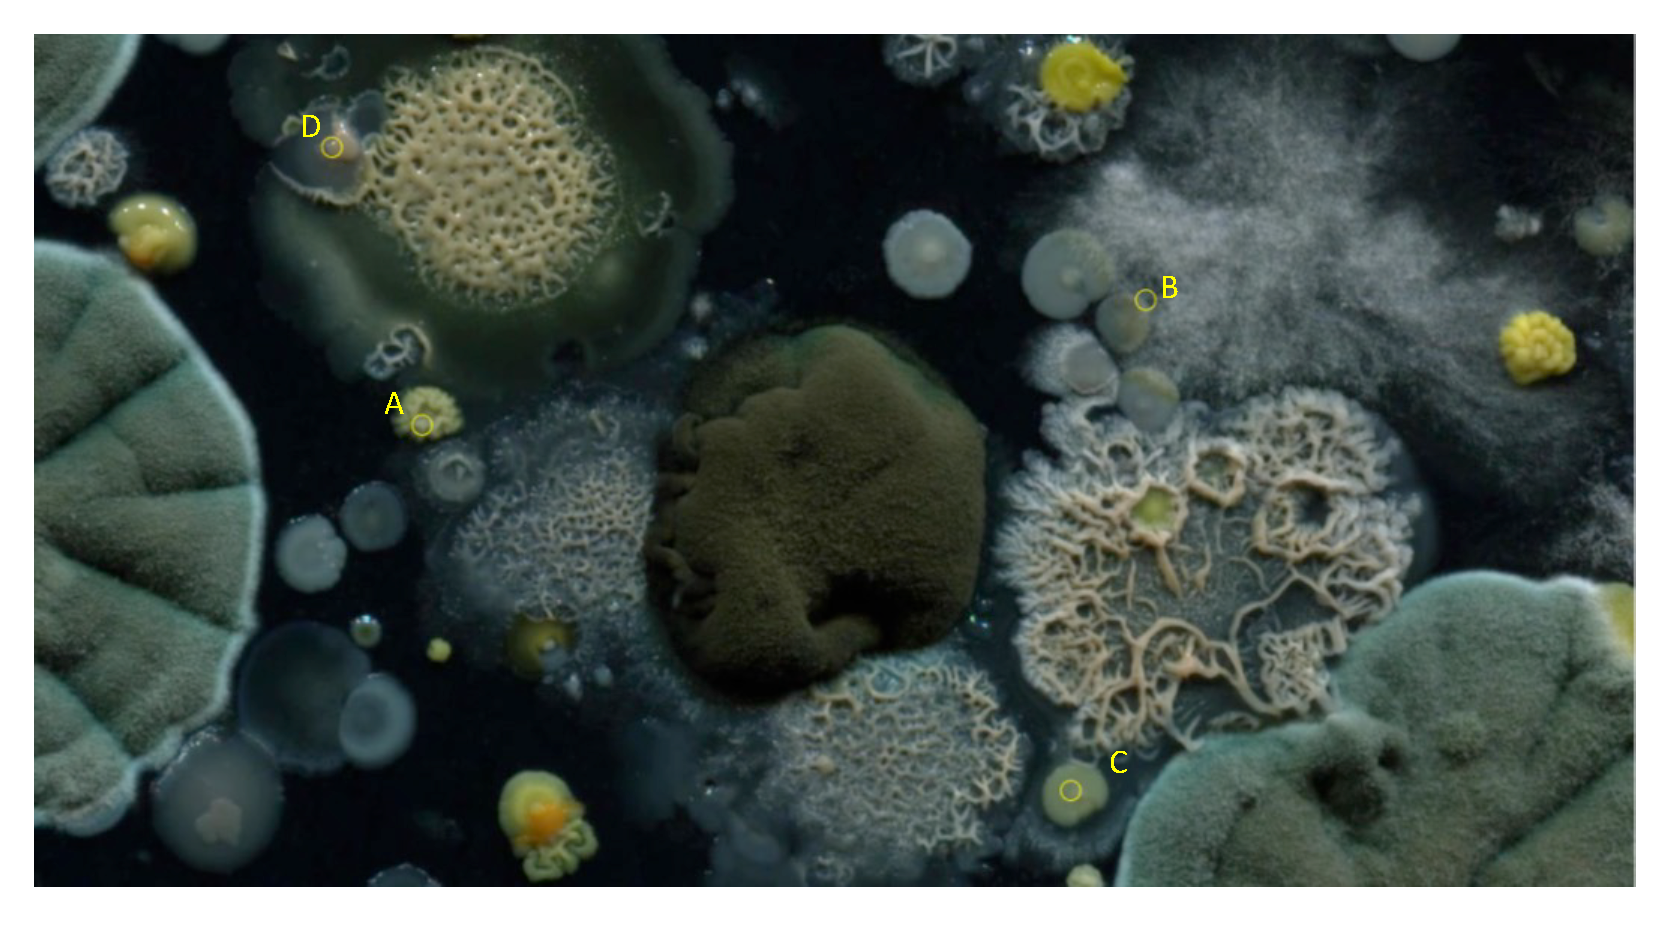
Sensors 20 02545 g018

Measurement and Modeling of Microbial Growth Using Timelapse Video
Abstract
1. Introduction
2. Methodology
2.1. Experimental Setup
2.2. Image-Based Measurement of Microbe Population and Generation of Experimental Population Curves
2.3. The Proposed Time-Shifted LFSD Exponent
2.4. The Parametric Image
3. Results
4. Conclusions
Author Contributions
Funding
Conflicts of Interest
References
- Sargent, J.R.; Bartley, C.; Dille, P.S.; Keller, J.M.; Nourbakhsh, I.; LeGrand, R. Timelapse GigaPan: Capturing, Sharing, and Exploring Timelapse Gigapixel Imagery. In Proceedings of the Fine International Conference on Gigapixel Imaging for Science, Pittsburgh, PA, USA, 11–13 November 2010; pp. 1–12. [Google Scholar]
- Gonzales, D.S.; Pinheiro, J.C.; Bavister, B.D. Prediction of the developmental potential of hamster embryos in vitro by precise timing of the third cell cycle. Reproduction 1995, 105, 1–8. [Google Scholar] [CrossRef] [PubMed]
- McKiernan, S.H.; Bavister, B.D. Environmental variables influencing in vitro development of hamster 2-cell embryos to the blastocyst stage. Biol. Reprod. 1990, 43, 404–413. [Google Scholar] [CrossRef] [PubMed]
- Schenk, D.; Bacher, S. Functional response of a generalist insect predator to one of its prey species in the field. J. Anim. Ecol. 2002, 71, 524–531. [Google Scholar] [CrossRef]
- Hurst, M.R.H.; van Koten, C.; Jackson, T.A. Pathology of Yersinia entomophaga MH96 towards Costelytra zealandica (Coleoptera; Scarabaeidae) larvae. J. Invertebr. Pathol. 2014, 115, 102–107. [Google Scholar] [CrossRef]
- Cobo, M.P.; Libro, S.; Marechal, N.; D’Entremont, D.; Cobo, D.P.; Berkmen, M. Visualizing bacterial colony morphologies using timelapse imaging chamber MOCHA. J. Bacteriol. 2018, 200, e00413-17. [Google Scholar]
- Dresbøll, D.B.; Thorup-Kristensen, K.; McKenzie, B.M.; Dupuy, L.X.; Bengough, A.G. Timelapse scanning reveals spatial variation in tomato (Solanum lycopersicum L.) root elongation rates during partial waterlogging. Plant Soil 2013, 369, 467–477. [Google Scholar] [CrossRef]
- Desai, N.; Ploskonka, S.; Goodman, L.R.; Austin, C.; Goldberg, J.; Falcone, T. Analysis of embryo morphokinetics, multinucleation and cleavage anomalies using continuous timelapse monitoring in blastocyst transfer cycles. Reprod. Biol. Endocrinol. 2014, 12, 54. [Google Scholar] [CrossRef] [PubMed]
- Shapiro, J.A.; Hsu, C. Escherichia coli K-12 cell-cell interactions seen by timelapse video. J. Bacteriol. 1989, 171, 5963–5974. [Google Scholar] [CrossRef] [PubMed]
- Delpretti, S.; Luisier, F.; Ramani, S.; Blu, T.; Unser, M. Multiframe sure-let denoising of timelapse fluorescence microscopy images. In Proceedings of the 5th IEEE International Symposium on Biomedical Imaging: From Nano to Macro, Paris, France, 14–17 May 2008. [Google Scholar] [CrossRef]
- Zhao, L.; Chen, Y.; Schaffner, D.W. Comparison of Logistic Regression and Linear Regression in Modeling Percentage Data. Appl. Environ. Microbiol. 2001, 67, 2129–2135. [Google Scholar] [CrossRef] [PubMed]
- Sartor, M.A.; Leikauf, G.D.; Medvedovic, M. LRpath: A logistic regression approach for identifying enriched biological groups in gene expression data. Bioinformatics 2008, 25, 211–217. [Google Scholar] [CrossRef] [PubMed]
- Meyer, P. Bi-logistic growth. Technol. Forecas. Soc. Chang. 1994, 47, 89–102. [Google Scholar] [CrossRef]
- Sheehy, J.E. Bi-Phasic Growth Patterns in Rice. Ann. Bot. 2004, 94, 811–817. [Google Scholar] [CrossRef] [PubMed]
- Meyer, P.S.; Ausubel, J.H. Carrying Capacity: A Model with Logistically Varying Limits. Technol. Forecast. Soc. Chang. 1999, 61, 209–214. [Google Scholar] [CrossRef]
- Wong, C.Y.; Goh, K.L. Catch-up models of science and technology: A theorization of the Asian experience from bi-logistic growth trajectories. Technol. Forecast. Soc. Chang. 2015, 95, 312–327. [Google Scholar] [CrossRef]
- Tsoularis, A.; Wallace, J. Analysis of logistic growth models. Math. Biosci. 2002, 179, 21–55. [Google Scholar] [CrossRef]
- Norton, L. A Gompertzian model of human breast cancer growth. Cancer Res. 1988, 48, 7067–7071. [Google Scholar] [PubMed]
- Achkar, J.M.; Fries, B.C. Candida Infections of the Genitourinary Tract. Clin. Microbiol. Rev. 2010, 23, 253–273. [Google Scholar] [CrossRef] [PubMed]
- Bauters, T.G.; Dhont, M.A.; Temmerman, M.I.; Nelis, H.J. Prevalence of vulvovaginal candidiasis and susceptibility to fluconazole in women. Am. J. Obstet. Gynecol. 2002, 187, 569–574. [Google Scholar] [CrossRef] [PubMed]
- Morrell, M.; Fraser, V.J.; Kollef, M.H. Delaying the Empiric Treatment of Candida Bloodstream Infection until Positive Blood Culture Results Are Obtained: A Potential Risk Factor for Hospital Mortality. Antimicrob. Agents Chemother. 2005, 49, 3640–3645. [Google Scholar] [CrossRef] [PubMed]
- Ahmad, A.; Khan, A.U. Prevalence of Candida species and potential risk factors for vulvovaginal candidiasis in Aligarh, India. Eur. J. Obstetr. Gynecol. Reprod. Biol. 2009, 144, 68–71. [Google Scholar] [CrossRef] [PubMed]
- Van Eck, W.; Lamers, M.H. Biological Content Generation: Evolving Game Terrains Through Living Organisms. In Evolutionary and Biologically Inspired Music, Sound, Art and Design; Springer International Publishing: Berlin, Germany, 2015; pp. 224–235. [Google Scholar] [CrossRef]

| Size of Are (Pixel) | Number of Pixels in the Area | ||
|---|---|---|---|
| 7 | 225 | ||
| 8 | 289 | ||
| 9 | 361 | ||
| 10 | 441 | ||
| 11 | 529 | ||
| 12 | 625 | ||
| 13 | 729 | ||
| 14 | 841 | ||
| 15 | 961 |
| Size of Are (Pixel) | Number of Pixels in the Area | |||
|---|---|---|---|---|
| 7 | 225 | |||
| 8 | 289 | |||
| 9 | 361 | |||
| 10 | 441 | |||
| 11 | 529 | |||
| 12 | 625 | |||
| 13 | 729 | |||
| 14 | 841 | |||
| 15 | 961 |
| r | Number of Pixels with |
|---|---|
| 2 | 376 |
| 4 | 229 |
| 8 | 85 |
© 2020 by the authors. Licensee MDPI, Basel, Switzerland. This article is an open access article distributed under the terms and conditions of the Creative Commons Attribution (CC BY) license (http://creativecommons.org/licenses/by/4.0/).
Share and Cite
Delibasis, K.; Basanou, I.; Boulogeorgos, A.-A.A. Measurement and Modeling of Microbial Growth Using Timelapse Video. Sensors 2020, 20, 2545. https://doi.org/10.3390/s20092545
Delibasis K, Basanou I, Boulogeorgos A-AA. Measurement and Modeling of Microbial Growth Using Timelapse Video. Sensors. 2020; 20(9):2545. https://doi.org/10.3390/s20092545
Chicago/Turabian StyleDelibasis, Konstantinos, Ifigenia Basanou, and Alexandros-Apostolos A. Boulogeorgos. 2020. "Measurement and Modeling of Microbial Growth Using Timelapse Video" Sensors 20, no. 9: 2545. https://doi.org/10.3390/s20092545
APA StyleDelibasis, K., Basanou, I., & Boulogeorgos, A.-A. A. (2020). Measurement and Modeling of Microbial Growth Using Timelapse Video. Sensors, 20(9), 2545. https://doi.org/10.3390/s20092545
